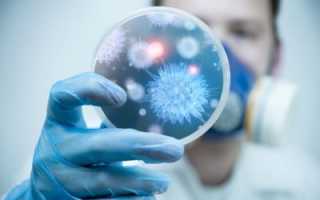

Одним из самых распространенных заболеваний верхних дыхательных путей является бронхит. Он может проявляться как у взрослых, так и у детей в виде различных признаков. При воспалительном процессе в бронхах начинается сильный кашель, который сохраняется на протяжении нескольких недель.
Основной причиной перехода заболевания из острой в хроническую стадию является несвоевременно начатое лечение.
Поэтому важно знать, как определить бронхит на начальной стадии в домашних условиях, чтобы не допустить осложнений.
Симптоматика в зависимости от причины заболевания
Бронхит характеризуется воспалением слизистой оболочки бронхов. Он может проявиться под влиянием различных факторов, среди которых выделяют:
острую респираторную вирусную инфекцию;
- грипп;
- аденовирусную инфекцию;
- хламидии, микоплазмы;
- бактериальную инфекцию;
- аллергены.
Поэтому признаки бронхита могут отличаться в зависимости источника заболевания. Выделяют несколько разновидностей болезни, которые диагностируются у взрослых и детей, а именно:
- При проникновении в дыхательные пути ядов и токсинов может появиться бронхит токсико-химического вида.
- Если отмечается поражение организма различными инфекциями грибкового или бактериального типа, то развивается инфекционный бронхит.
Осложнением после ОРВИ, гриппа является вирусная форма заболевания. Она может образоваться под влиянием аденовируса, парагриппозных, респираторно-синцитиальных и других вирусных инфекций.
- Под влиянием микобактерий туберкулеза начинается туберкулезный бронхит.
- У детей и взрослых, подверженных аллергическим реакциям, может появиться аллергический бронхит. Если лечение не будет начато вовремя, он переходит в обструктивную стадию, а иногда и в астму.
Чтобы правильно назначить медикаментозную терапию, необходимо выяснить, как проявляется каждый из вышеуказанных видов.
Врачи отмечают, что симптомы бронхита могут значительно варьироваться в зависимости от его типа. Острый бронхит, как правило, проявляется сильным кашлем, который может сопровождаться выделением мокроты, а также общей слабостью и повышенной температурой. Хронический бронхит, в свою очередь, характеризуется постоянным кашлем, который длится более трех месяцев в году и повторяется на протяжении двух лет. Врачи подчеркивают, что при обострении хронического бронхита могут возникать одышка и свистящие звуки при дыхании. Аллергический бронхит часто сопровождается зудом в горле и насморком, что делает его схожим с симптомами простуды. Важно своевременно обратиться к специалисту для точной диагностики и назначения адекватного лечения, так как игнорирование симптомов может привести к серьезным осложнениям.

Инфекционный бронхит
Инфекционный вид заболевания является одним из самых распространенных у взрослых и детей. Он образуется под воздействием различных микроорганизмов бактериальной, вирусной или грибковой природы.
Симптомы зависят от характера течения заболевания. При возникновении легкой формы у больного отмечаются:
сухой кашель, который иногда переходит во влажную форму;
- ослабление организма, усталость;
- неприятные ощущения в груди;
- подъем температуры до субфебрильных отметок (иногда гипертермия);
- сухие хрипы;
- жесткость дыхания.
Когда появляются первые симптомы заболевания, лабораторная диагностика может не дать результатов. Ведь в крови не обнаруживаются показатели, указывающие на бронхит.
С изменением стадии заболевания признаки у взрослых могут выражаться по-иному. Если бронхит переходит в среднетяжелую степень, то отмечается их усиление. Среди них выделяют:
- сильный кашель;
- напряжение и болезненные ощущения в области груди и живота;
- недомогание и ослабление организма сильной степени;
- затруднение дыхания;
- отхождение мокроты, содержащей гной или слизь с гноем;
- жесткое дыхание;
- сухость хрипов, переходящую в мелкопузырчатую влажность.
Распознать в домашних условиях начало инфекционного бронхита в большинстве случаев несложно. Ему обычно предшествует вирусное, бактериальное заболевание. Бронхит в данном случае является осложнением.
При заболевании, вызванном вирусным поражением, отмечаются некоторые характерные симптомы, например:
На начальном этапе кашель отличается сухостью. Спустя несколько дней начинает отходить мокрота прозрачного или бледно-желтого цвета.
- Процесс дыхания усложняется, появляются хрипы, удлиненный выдох.
- Отмечается сонливость, снижение аппетита.
- У больного наблюдаются заложенность носа, слизистые выделения из носовых проходов, покраснение задней стенки носоглотки.
- Температура тела повышается до 38,5-39°С.
Лихорадка продолжается до 3 дней. От возникновения первых признаков до окончания заболевания проходит от 1 до 3 недель.
Если бронхит вызван бактериальным возбудителем, то симптомы немного отличаются, а именно:
- Кашель у взрослых на начальном этапе умеренный, сухой. С развитием наблюдается появление мокроты (через 3-4 дня). Она отходит скудно, отличается густой консистенцией, гнойным характером, желто-зеленым цветом.
- Дыхание становится учащенным, появляется одышка. Наблюдаются влажные и сухие хрипы.
- Человек становится вялым, капризным, ощущаются мышечные и головные боли.
- Температура повышается постепенно до 38°С и выше. Лихорадка может длиться дольше, чем при вирусном поражении.
Заболевание протекает в период от 2 до 4 недель.

Аллергический бронхит
У человека, склонного к аллергии, нередко отмечается аллергический вид бронхита. Симптомы заболевания появляются под влиянием распространенных аллергенов, например:
- пыльцы растений;
- шерсти и перьев животных;
- бытовой пыли;
- парфюмерии;
- косметических средств;
- бытовой химии.
Распознать бронхит не составит труда. Ведь при устранении контакта с раздражителем симптомы проходят самостоятельно без какого-либо лечения.
Одной из особенностей такого вида болезни является отсутствие гнойного отделяемого.

- сухие хрипы рассеянного типа;
- появление одышки на выдохе;
- кашель под влиянием аллергенов;
- нарушение дыхательной функции;
- смену периодов ремиссии и обострения при устранении или возобновлении контакта с раздражающим веществом.
Бронхит — это воспаление бронхов, которое может проявляться в различных формах, и симптомы могут варьироваться в зависимости от типа заболевания. Люди часто отмечают, что острый бронхит начинается с сухого кашля, который со временем становится влажным, сопровождаясь выделением мокроты. При этом может наблюдаться общая слабость и повышение температуры. Хронический бронхит, напротив, характеризуется постоянным кашлем, который длится более трех месяцев в году на протяжении двух лет. Пациенты жалуются на одышку, особенно при физической нагрузке, и ощущение стеснения в груди. Аллергический бронхит может проявляться в виде приступов кашля и свиста при дыхании, особенно в сезон цветения. Важно помнить, что при появлении симптомов следует обратиться к врачу для точной диагностики и назначения адекватного лечения.

Токсико-химический бронхит
Признаки бронхита токсико-химического типа проявляются после вдыхания вредных веществ. Такими соединениями становятся кислоты, органическая или неорганическая пыль, угарный, сернистый газы.
Первые симптомы проявляются в виде ухудшения состояния человека. Он резко теряет интерес к еде, отмечаются сильные головные боли. При дальнейшем воздействии вредных веществ обнаруживаются:
мучительный кашель;
- сильная одышка, иногда приводящая к удушью;
- дыхательная недостаточность;
- кислородное голодание организма;
- посинение слизистых оболочек;
- сухие хрипы;
- жесткое дыхание;
- болезненные ощущения в груди колющего типа.
Важным этапом устранения опасных признаков у взрослых является исключение вредного воздействия. Только после этого назначается симптоматическая терапия.
Признаки различных форм бронхита
В зависимости от степени выраженности признаков и характера течения выделяют острый, хронический и обструктивный бронхиты. Симптомы заболевания у взрослых могут отличаться. Выявить каждую форму самостоятельно в домашних условиях можно, ориентируясь на характерные проявления.
Острый бронхит
Острый бронхит протекает без обструкции, начинаясь с сухого частого кашля, который постепенно перетекает во влажный. В результате откашливания отходит мокрота.
Выявить заболевание можно по изменению дыхания. Оно становится:
- жестким;
- с приступами хрипов;
с удлиненным выдохом.
При этом отсутствуют признаки дыхательной недостаточности и одышки.
Меняется общее состояние больного. У взрослых отмечаются:
- подъем температуры тела до 38-38,5°С;
- ослабление организма;
- повышенная потливость;
- болезненные ощущения в груди;
- першение в горле, сопровождающееся жжением;
- головная боль;
- сопутствующие заболевания (фарингит, ларингит, конъюнктивит);
- обезвоживание организма за счет гипертермии.
Острая стадия заболевания длится около двух недель.
Хронический бронхит
Хронический бронхит является последствием несвоевременного лечения острой формы заболевания. В этом случае появляется мучительный кашель, который беспокоит пациента более 12 недель в году. Обычно он глубокий, глухой, проявляется после пробуждения. Откашливание сопровождается обильным выходом слизи из бронхов.
Хроническое течение болезни не сопровождается гипертермией.
Повышение температуры тела наблюдается на уровне субфебрильных отметок. Если подъем и наблюдается до высоких отметок, обычно он кратковременный.

Выделяют и специфические симптомы хронического типа. Одним из них является одышка, которая может усиливаться. Она обусловлена постепенной обструкцией бронхов.
При кашле могут появиться кровянистые выделения вместе с мокротой. В этом случае обязательно необходимо посетить врача, чтобы исключить туберкулез или онкологические заболевания.
При длительном течении хронического бронхита может появиться хроническая обструктивная болезнь легких.
Обструктивный бронхит
При обструктивном бронхите наблюдается снижение проходимости и закупоривание бронхов. Процесс обусловлен скоплением слизи, отечностью тканей или бронхоспазмом.

- сухостью;
- надрывностью;
- приступами;
- усилением в ночное время.
При сильных приступах может появиться тошнота и рвота, слезотечение.
Дыхание становится свистящим. При этом выдох значительно затруднен. При прослушивании у пациента определяются хрипы в легких. В процессе дыхания задействованы мышцы ключиц, шеи, груди.В горле отмечается першение и жжение.
Лихорадка носит умеренный характер. На начальном этапе возникновения заболевания наблюдается гипертермия. Впоследствии температура нормализуется или снижается до субфебрилитета.

Заболевание протекает в зависимости от характера лечения и выраженности симптомов. В среднем признаки наблюдаются на протяжении 10-21 дней.
Бронхит необходимо выявить на ранней стадии. Если он будет запущен, то может появиться осложнение в виде бронхиолита или других заболеваний. Поэтому появившийся кашель, который не проходит в течение нескольких дней, требует немедленного обращения к врачу. Он проведет диагностику и назначит лечение в соответствии с видом заболевания.
Вопрос-ответ
Какие основные симптомы острого бронхита?
Основные симптомы острого бронхита включают кашель, который может быть сухим или с выделением мокроты, одышку, хрипоту, а также общее недомогание и повышенную температуру тела. Кашель может сохраняться несколько недель после исчезновения других симптомов.
Как отличить хронический бронхит от острого?
Хронический бронхит характеризуется постоянным кашлем с выделением мокроты, который продолжается не менее трех месяцев в году на протяжении двух последовательных лет. В отличие от острого бронхита, симптомы хронического бронхита могут ухудшаться в холодное время года и часто связаны с курением или длительным воздействием раздражителей.
Какие дополнительные признаки могут указывать на бронхит у детей?
У детей симптомы бронхита могут включать не только кашель и одышку, но и затрудненное дыхание, свистящие звуки при дыхании, а также повышенную утомляемость. Важно также обратить внимание на изменение аппетита и общее состояние ребенка, так как бронхит может вызывать лихорадку и ухудшение самочувствия.
Советы
СОВЕТ №1
Обратите внимание на характер кашля. При бронхите кашель может быть сухим или влажным. Если он длится более трех недель или сопровождается выделением гнойной мокроты, обязательно обратитесь к врачу для диагностики и назначения лечения.
СОВЕТ №2
Следите за температурой тела. Повышение температуры может указывать на инфекционную природу бронхита. Если температура превышает 38°C и держится несколько дней, это повод для обращения к специалисту.
СОВЕТ №3
Обратите внимание на одышку и свистящие дыхания. Если вы замечаете, что вам становится трудно дышать или появляется свист при дыхании, это может быть признаком обострения бронхита и требует немедленного медицинского вмешательства.
СОВЕТ №4
Не игнорируйте общие симптомы, такие как усталость и слабость. Эти признаки могут свидетельствовать о том, что ваше тело борется с инфекцией. Важно обеспечить себе отдых и, при необходимости, обратиться к врачу для получения рекомендаций по лечению.
 острую респираторную вирусную инфекцию;
острую респираторную вирусную инфекцию; Осложнением после ОРВИ, гриппа является вирусная форма заболевания. Она может образоваться под влиянием аденовируса, парагриппозных, респираторно-синцитиальных и других вирусных инфекций.
Осложнением после ОРВИ, гриппа является вирусная форма заболевания. Она может образоваться под влиянием аденовируса, парагриппозных, респираторно-синцитиальных и других вирусных инфекций. сухой кашель, который иногда переходит во влажную форму;
сухой кашель, который иногда переходит во влажную форму;
 На начальном этапе кашель отличается сухостью. Спустя несколько дней начинает отходить мокрота прозрачного или бледно-желтого цвета.
На начальном этапе кашель отличается сухостью. Спустя несколько дней начинает отходить мокрота прозрачного или бледно-желтого цвета.
 мучительный кашель;
мучительный кашель; с удлиненным выдохом.
с удлиненным выдохом.